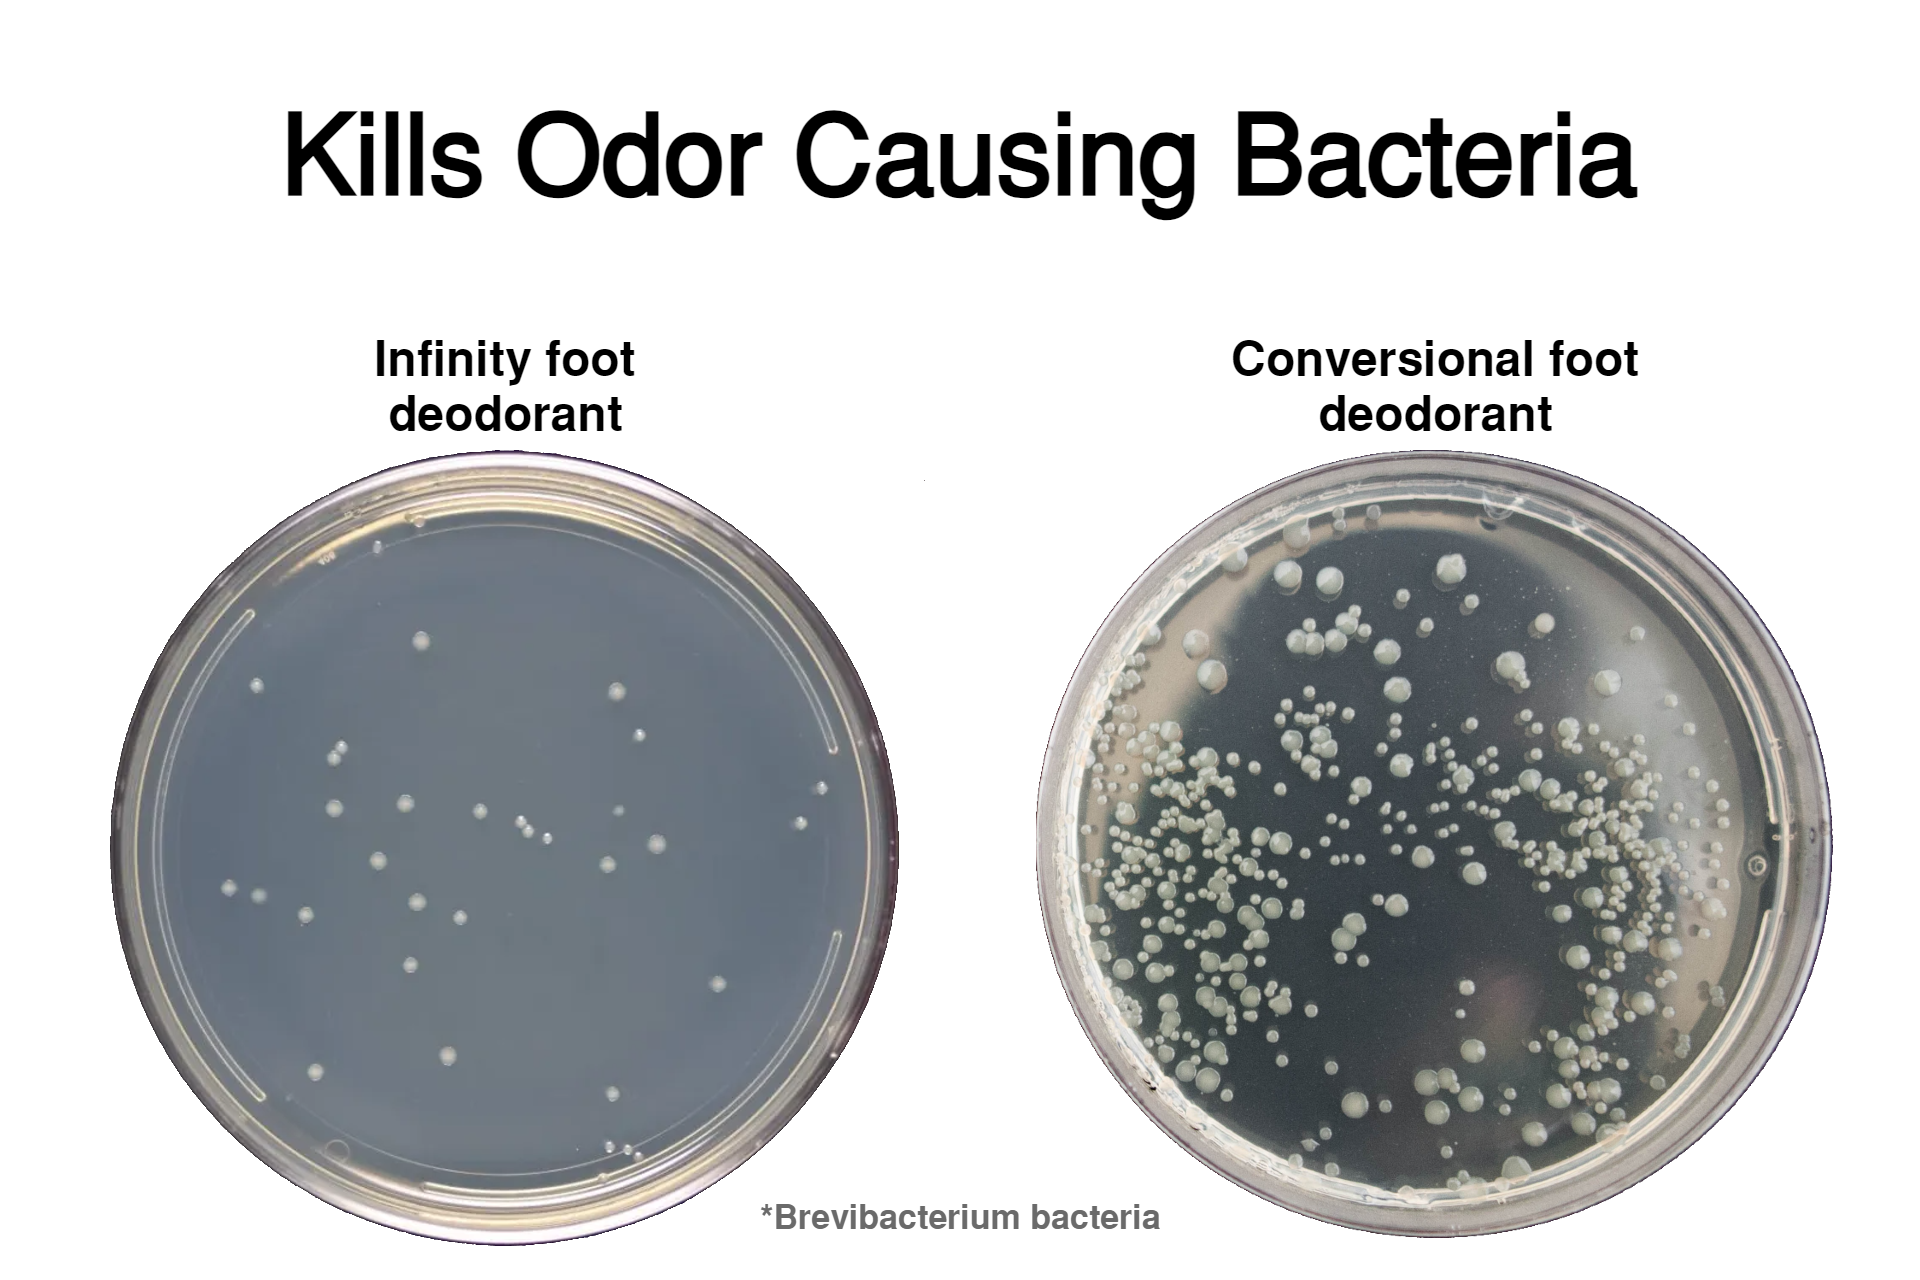

Powerful Protection
With Infinity technology, our formula is designed to keep you fresh all day long
Free Shipping
Free U.S. shipping on $25+
Hassle-free Returns
30 Days Return Window
World-class Customer Service
Backed by Leap Cosmetics